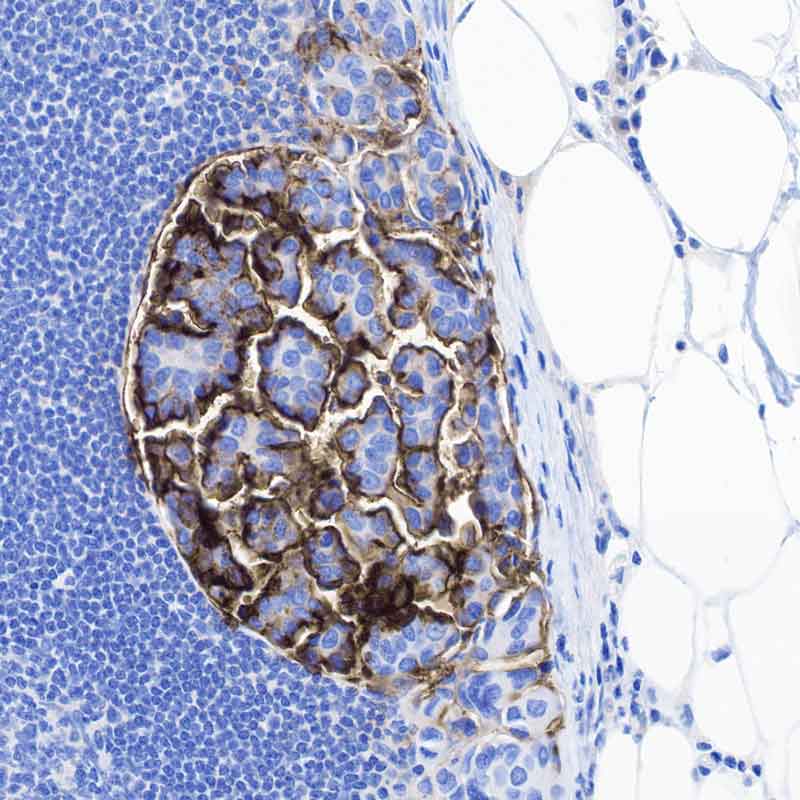

Science Clears the Way to Treating the Trickiest Bladder Cancers
Bladder tumors that have been excluded from clinical trials have a few things in common that could lead to new therapies.
Scientists at UC San Francisco have found a way to identify and possibly treat a mysterious type of bladder cancer that affects up to 1 in 4 cases.
First, they found a marker on the surface of the tumor cells that until now had only been associated with ovarian cancer; then they designed CAR-T therapy to kill the tumors in mice.
The discovery, which was made possible through funding from the National Institutes of Health (NIH), appears June 17 in Nature Communications.
“Unlike conventional bladder cancer, which has a consistent look under the microscope and succumbs predictably to therapy, the deadliest bladder tumors, collectively known as histologic variant (HV) bladder cancer, each look very different and can only be effectively treated with surgery,” said Sima Porten, MD, an associate professor of urology at UCSF and co-senior author of the paper.
Far too often, however, these tumors grow back.
Using a sequencing technology developed in-house, the researchers analyzed gene expression in single cells in conventional and HV bladder tumors from patients at UCSF. They found that most HV tumors, regardless of subtype, had cells that expressed CA125, which is associated with ovarian cancer. Conventional bladder tumors did not have these cells.
Variations in bladder cancer tumors
Conventional bladder cancer

Conventional bladder cancer (urothelial carcinoma), as seen on the left, accounts for 75% of all bladder cancer, and is easily treated with a variety of therapies.
Histologic variant (HV) bladder cancers
The remaining 25% of bladder cancers (known as histologic variant, or HV, bladder cancer) have quirky appearances under the microscope, complicating efforts to understand and treat them. UCSF researchers found new commonalities among these tumors that could lead to the first new therapies against them.
One example is a protein called CA125 (seen in the darker shaded areas to the left and below), which only appears with HV tumors, but not conventional bladder tumors.


Images by Kevin Lu, MD, PhD
The HV tumors also had a protein, TM4SF1, on the surface of their cells. Immune cells engineered to home in on TM4SF1 successfully tracked down these tumors in mice and destroyed them — a sign that such immunotherapy could someday be useful in treating the cancer.
The discovery holds immense promise for patients. HV tumors are often excluded from clinical trials due to their diverse appearances, precluding the development of new therapies.
“Our lab’s single cell sequencing technology enabled us to go from patient biopsies to laboratory testing and back to a promising therapy in just a few years,” said Franklin Huang, MD, PhD, an oncologist and professor of medicine and urology at UCSF who is a co-senior author of the paper. “We think this could finally move the needle for patients with HV bladder cancer, who typically have very few options for treatment.”
Authors: Lead authors are Heiko Yang, MD, PhD, Hanbing Song, PhD, both at UCSF. Other UCSF authors are Elizabeth Yip, Timothy Gilpatrick, MD, PhD, Kevin Chan, Paul Allegakoen, MS, Kevin L. Lu, MD, PhD, Keliana Hui, Julia Pham, Corynn Kasap, MD, PhD, Vipul Kumar, MD, PhD, Janae Gayle, Bradley A. Stohr, MD, PhD, Chien-Kuang Cornelia Ding, MD, PhD, Arun P. Wiita, MD, PhD, Maxwell V. Meng, MD, and Jonathan Chou, MD, PhD.
Funding: This project was supported by the Chan-Zuckerberg Biohub San Francisco, the UCSF Department of Medicine, the National Institutes of Health (TL1DK139565, U2CDK133488), the Urology Care Foundation, and the California Urology Foundation.
Variations in bladder cancer tumors
Conventional bladder cancer
Conventional bladder cancer (urothelial carcinoma), as seen below, accounts for 75% of all bladder cancer, and is easily treated with a variety of therapies.

Histologic variant (HV) bladder cancers
The remaining 25% of bladder cancers (known as histologic variant, or HV, bladder cancer) have quirky appearances under the microscope, complicating efforts to understand and treat them. UCSF researchers found new commonalities among these tumors that could lead to the first new therapies against them.
One example is a protein called CA125 (seen in the darker shaded areas seen below), which only appears with HV tumors, but not conventional bladder tumors.



Images by Kevin Lu, MD, PhD
The HV tumors also had a protein, TM4SF1, on the surface of their cells. Immune cells engineered to home in on TM4SF1 successfully tracked down these tumors in mice and destroyed them — a sign that such immunotherapy could someday be useful in treating the cancer.
The discovery holds immense promise for patients. HV tumors are often excluded from clinical trials due to their diverse appearances, precluding the development of new therapies.
“Our lab’s single cell sequencing technology enabled us to go from patient biopsies to laboratory testing and back to a promising therapy in just a few years,” said Franklin Huang, MD, PhD, an oncologist and professor of medicine and urology at UCSF who is a co-senior author of the paper. “We think this could finally move the needle for patients with HV bladder cancer, who typically have very few options for treatment.”
Authors: Lead authors are Heiko Yang, MD, PhD, Hanbing Song, PhD, both at UCSF. Other UCSF authors are Elizabeth Yip, Timothy Gilpatrick, MD, PhD, Kevin Chan, Paul Allegakoen, MS, Kevin L. Lu, MD, PhD, Keliana Hui, Julia Pham, Corynn Kasap, MD, PhD, Vipul Kumar, MD, PhD, Janae Gayle, Bradley A. Stohr, MD, PhD, Chien-Kuang Cornelia Ding, MD, PhD, Arun P. Wiita, MD, PhD, Maxwell V. Meng, MD, and Jonathan Chou, MD, PhD.
Funding: This project was supported by the Chan-Zuckerberg Biohub San Francisco, the UCSF Department of Medicine, the National Institutes of Health (TL1DK139565, U2CDK133488), the Urology Care Foundation, and the California Urology Foundation.
